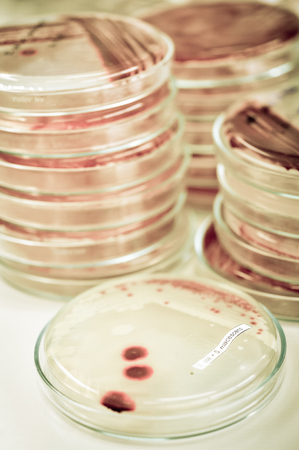
microbiology laboratory test with old color styleの写真素材

写真素材 - microbiology laboratory test with old color style
キーワード
- agar
- antibiotic
- bacteria
- bacterial
- biology
- biotechnology
- blue
- chemical
- colony
- culture
- dish
- drug
- education
- experiment
- experimental
- fungi
- grow
- growth
- healthcare
- investigation
- lab
- laboratory
- macro
- medical
- medicine
- microbiology
- microorganisms
- molecular
- organism
- penicillin
- penicillum
- petri
- plate
- research
- science
- strain
- study
類似作品
Bottles with gl...
Two Petri dishe...
Many Old Medica...
Making bacterio...
Laboratory assi...
young scientist...
microbiology la...
The hands of a ...
Academic labora...
property and ut...
microbial cultu...
Retro golden mi...
Laboratory assi...
University labo...
Stacks of Petri...
Various culture...
Researchers wor...
Research of vir...
Lab table with ...
Close up on tes...
Medical science...
close-up of pet...
pile of agar pe...
Blood test tube...
Old flasks in a...
Bacterial Inocu...
Microbiology ha...
Photo Laborator...
medical technol...
Laboratory tech...
test-tubes with...
Lab bench with ...
Microbiology La...
Backgrounds of ...
Close-up of bac...
Close-up of bac...
Mold growing in...
The evolution o...
school laborato...
experiments and...
petri dish with...
Laboratorian in...
Microbiology co...
Streak plate fo...
Microbiology la...
Agar plates and...
Scientist analy...
Medical technic...
A black-gloved ...